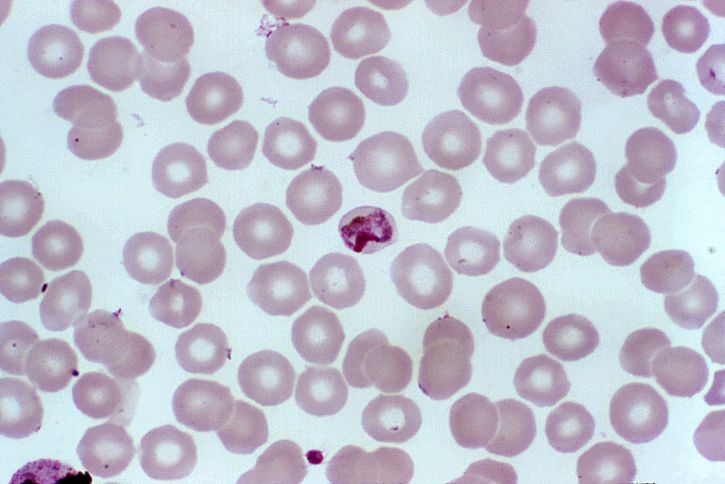

Veli Pekka Toropainen
Luterilaisen puhdasoppisen 1600-luvun yhteisön tukipilarina oli perhe, jonka rakenne noudatti yhteiskunnan rakennetta. Siinä isä kuningas oli ylimpänä ja säädyt jokainen asemansa mukaisessa järjestyksessä. Samoin perheessä isä oli ylinnä käyttämässä isännänvaltaa ylitse kaikkien taloutensa jäsenien. Perheen äidillä oli isännänvallan alainen emännänvalta, jota alempien tuli myös totella ehdoitta. Emännällä oli myös isännänvalta käytössään isännän ollessa poissa. Lapset, palkolliset ja muut talouden jäsenet olivat näiden kahden ehdottoman vallan alaisia.
Kotikuri varmisti valtarakenteiden säilymisen. Sillä ehkäistiin väärinkäytöksiä ja palautettiin rikkurit ruotuun. Kotikuri käsitti myös fyysisen kurittamisen, mutta varsinaista väkivaltaa ei tarvinnut sietää. Kotikurin piiriin ei luettu hakkaamista, joka aiheutti laillakin kielletyn pysyvän ruumiinvamman tuottamisen. Kotikurin tuli myös pysyä sellaisissa rajoissa, ettei sen harjoittaminen häirinnyt naapurustoa. Siitä johtuvat häiritsevät äänet ja pahoinpidellyn pakenemiset naapureiden suojiin luettiin tällaisiksi tekijöiksi.
Yleensä parempana keinona pitää väki kurissa pidettiin opettamista ja kasvattamista. Ydinperhettä kuvailtiin runollisesti esimerkiksi niin, että isäntä oli talo, jota emäntä ympäröi hedelmällisenä viiniköynnöksenä. Hyvin kuritetut ja opastetut lapset kasvoivat ja kukoistivat kuten Libanonin setripuut. Yhtä kaikki talouden jäsenillä – piioilla, rengeillä, oppipojilla ja kisälleillä – ei ollut oikeutta omavaltaiseen toimintaan, eivätkä he saaneet poistua kodin ulkopuolelle ilman isännän tai emännän lupaa. Poikkeamat normaalitilanteista aiheuttivat helposti väkivallan uhan, jota käsittelen tässä artikkelissa.

Aviopuolisoiden välinen väkivalta
Avioliiton perusideaali oli rakkauden täyttämä yhteiselo. Avioliittoon ei saanut pakottaa, vaan puolisoiden välillä tuli olla rakkautta jo ennen avioitumista. Kyse ei ollut mistään romanttisesta rakkaudesta, vaan lähinnä toisen sietämisestä. Rakkauden ja kiintymyksen katsottiin kasvavan puolisoiden välille avioliiton myötä. Käytännössä näin ei kuitenkaan aina ollut, vaan avioparit saattoivat olla riitaisia jo avioliiton solmimisesta lähtien tai sitten heidän välinsä kehittyivät väärään suuntaan.
Miehen ei kuulunut kurittaa vaimoaan turhaan, vaan hänen tuli opastaa ja kasvattaa tätä kärsivällisesti tämän asemassa. Vaimon tuli olla nöyrä ja kuuliainen, mitä kaikki naiset eivät suinkaan olleet. Mikäli mies ei kyennyt pitämään vaimoaan kurissa, joutui hän naurunalaiseksi muiden silmissä. Mikäli vaimo kohteli miestään huonosti, siunailtiin asiaa Jumalan säätämän järjestyksen rikkomisena. Ja kaiken yllä leijui Jumalan koston miekka, joka saattoi tärkeän harmonian vaaraan. Rangaistuksena yksittäisten ihmisten synneistä Jumala lähetti ruoskansa kurittamaan kaikkia kollektiivisesti rutolla, sodalla, tulipalolla tai nälänhädällä. Tätä taustaa vasten seuraavat esimerkit osoittautuvat pahoiksi rikkeiksi vallitsevaa harmoniaa vastaan.

Vuonna 1649 vaimo Agnes Jöransdotter valitti kämnerinoikeudelle, että hänen miehensä Jakob Thomasson Snickare oli hylännyt hänet kolme vuotta aiemmin palattuaan Tanskan sodasta. Mies oli asettunut tuolloin siihen tupaan, jossa hänen isänsä asui ja maannut siellä yönsä penkillä, eikä tullut vaimonsa kanssa vuoteeseen. Sieltä hän oli muuttanut vastapäätä olleeseen tupaan ja pitänyt aina sen avaimen itsellään. Tuvan kamarissa asui myös ratsumiehen leski Karin Olofsdotter, jonka mies oli kaatunut kauan aikaa sitten Saksassa.
Seuraavana kesänä Jakob oli muuttanut Karinin kamariin ja elänyt siitä lähtien yhdessä tämän kanssa. Jakob ja Karin eivät voineet kieltää tätä, mutta Jakob kielsi koskaan maanneensa yhdessä Karinin kanssa. Sen sijaan hänellä oli aina ollut vuoteessaan kaksi poikaansa, joista toinen oli niin vanha, että hän kävi koulua ja oli nyt matkustanut Ruotsiin.
Todistajaksi kutsuttu Olof Hirven vaimo kertoi Jakobin pysytelleen erossa vaimostaan. Tämä oli tullut yhden ainoan kerran vaimonsa asumaan tupaan aikomuksenaan lyödä vaimoaan. Karin Olofsdotter oli seurustellut todistajan mukaan Jakobin kanssa kuin olisi tämän vaimo, käynyt hänen avaimensa vyöllään ja keittänyt sekä valmistanut tälle joka päivä ruokaa. Sitä todistaja ei tiennyt, olivatko he jakaneet myös vuoteen. Jakobin vaimo Agnes kertoi samoin.
Jakob vastasi, että syy oli kyllä hänessä, sillä hän ei voinut sietää vaimoaan, joka oli hävittänyt ja ryypännyt kaiken mitä hänellä oli hänen ollessaan Tanskassa. Vaimo ei voinut kieltää tätä, mutta hän sanoi, että hänen oli elätettävä neljä pientä lasta miehen ollessa poissa. Kysyttäessä Agnes sanoi, että hän tyytyisi siihen, että hänen miehensä muuttaisi takaisin hänen luokseen ja että Karin muuttaisi pois talosta.

Mestari Marcus Pauli Zadlerus kertoi kesäkuussa 1662, että kun hän asui edellisenä vuonna Frantsilan talossa, olivat isäntä Simon Persson Frantsila ja emäntä Cecilia Simonsdotter Frantsila joutuneet keskenään riitaan. Tuolloin toisella oli ollut kädessään puukko ja toisella halko. Vaimo oli sanonut miehelleen: ”Sinä papin lehmävaras, sinä, joka veit lehmän Nummen pellolta ja teurastit sen Nummen metsässä, nyt sinä haluat teurastaa minutkin!”
Zadlerus ei ollut halunnut jäädä riitelijöiden jalkoihin, vaan oli mennyt oluelle naapuriin. Myös Markus Styrmanin lesken Sara Larsdotterin luona hän oli saanut kuulla Frantsilan väen tappelevan keskenään. Frantsilat kielsivät tällaisen, mutta vaimo Cecilia sanoi lopulta riitelevänsä miehensä kanssa toisinaan. Styrmanin leski kertoi puolestaan, että hän oli kuullut Cecilia Frantsilan kutsuneen miestään ainoastaan varkaaksi ja pyövelinruoaksi.

Vaimo Brita Brusiusdotter valitti tammikuussa 1665 korkeasti miehensä ratsumies Jöran Sigfridsson Karan ajaneen hänet usein talosta miekalla ja puukolla uhaten. Lisäksi mies oli lyönyt häntä, kun vaimo oli kieltänyt tätä seurustelemasta Lars Henriksson Fråstin naimisissa olevan tyttären Ingeborg Fråstin kanssa. Vaimo Brita epäili miehellään olevan luvatonta kanssakäymistä Ingeborgin kanssa, sillä mies tapasi ryypätä tämän luona. Mies oli usein jäänyt yöksi Ingeborgin luo ja kun vaimo Brita oli mennyt noutamaan tätä kotiin, oli hän pahoinpidellyt vaimoaan Ingeborgin neuvosta. Myös Ingeborg oli hyökännyt hänen kimppuunsa kadulla samasta syystä ja lyönyt hänen nenänsä ja suunsa verille.
Britan mukaan kaikki oli alkanut jo ennen heidän avioliittoaan, kun Jöran oli kerran pantannut Ingeborgin soljen Pyrrin kellariin saadakseen olutta. Makaaminen oli tapahtunut tuolloin kreivi Wittenbergin talossa, jossa Jöran oli juonut oluensa. Jöran vastasi tähän, ettei hän ollut juonut yksin, joten väitetty makaaminen oli mahdottomuus. Brita kertoi edelleen, että kun hänen miehensä oli neljä vuotta aiemmin viipynyt reissullaan kolme yötä poissa kotoa, oli Brita etsinyt häntä Fråstin luota kello neljä aamulla. Fråstin vaimo oli kieltänyt Jöranin olevan talossa, mutta kun Brita oli koputtanut saunan oveen, oli Ingeborg tullut avaamaan pelkässä paidassa ja Britan mies Jöran oli maannut lavolla pelkässä paidassa. Ingeborg oli kieltäytynyt päästämästä Britaa sisään ja pyytänyt Jörania lyömään vaimoaan. Tämä olikin tehnyt niin ja paikalle oli vaadittu naapureita pelastamaan Brita.
Brita Brusiusdotter oli aikonut mennä valittamaan miehestään pormestarille, mutta Lars Stadstienaren anoppi Karin oli neuvonut häntä jättämään asian sikseen. Sen talven Jöran oli pysytellyt lähes kokonaan erossa Ingeborgista. Jöran kertoi kyllä maanneensa tuolloin Fråstin saunassa, mutta yksin, sillä Ingeborg makasi miehensä Johanin kanssa, joka nyt oli karkuteillä sotapalveluksesta. Vaimolleen hän oli antanut joitakin korvapuusteja, sillä tämä soitti hänelle turhaan suutaan.
Brita kertoi edelleen, että hänen miehensä oli ollut edellisenä syksynä ryyppäämässä Ingeborgin luona ja Brita itse oli mennyt hakemaan häntä ja rikkonut ikkunan käskien miestään tulemaan pois huoran seurasta. Ingeborg oli tällöin lyönyt Britaa kasvoihin kadulla sanoen antaneensa huoran merkin Britalle. Tähän Jöran vastasi, ettei kukaan voinut kieltää häntä juomasta omia rahojaan. Brita jatkoi, että hänen miehensä oli murtanut arkun ja ottanut sieltä kymmenen markan plootun sekä juonut sen ja maksanut sillä Fråstin ikkunan.
Mies oli sanonut, että hän kävisi Fråstilla, vaikka vaimo tukehtuisi harmiinsa. Mies kielsi muun, mutta sanoi ottaneensa rahan maksaaksensa velkansa. Nyt edellisenä iltana Brita sanoi huomanneensa, että hänen miehellään oli Ingeborgin hiuksista tehty rannekoru ranteessaan. Jöran kielsi tämän, mutta Ingeborg sanoi Jöranin ottaneen san hänen sisareltaan Elin Fråstilta. Brita pyysi viimeiseksi, että hänen miestään kiellettäisiin pitämästä yhtä huora Ingeborgin kanssa.
Jöran Kara pääsi kostamaan vaimolleen, sillä hän väitti tämän puolestaan maanneen naimisissa olleen ylioppilas Sigfridus Simoniksen kanssa. Kun asia näytettiin toteen, sai Brita käydä kuolemaan kaksinkertaisesta huoruudesta. Myös Sigfridus tuomittiin kuolemaan, mutta kun hänen mestauksensa epäonnistui, karkotettiin hänet kaupungista. Jöran Kara itse selvisi tekosistaan sakoilla.

Tullimies Johan Kellaren leskeä Maria Jöransdotteria epäiltiin miehensä tappamisesta ja raastuvanoikeus antoi 11. toukokuuta 1695 asiassa välituomion. Vaimo kielsi olevansa syypää miehensä kuolemaan. Hän kertoi olleensa Jakob Vääräjalan luona käymässä, kun hänen miehensä oli aamulla kello seitsemän aikaan pudonnut vuoteesta ja kolhinut päänsä kahteen lattialla olleeseen pataan sillä seurauksella, että hän oli kuollut. Tämän vaimo halusi todistaa oman tyttärensä ja Johanin tytärpuolen Anna Johansdotterin kertomuksella.
Vaimo Maria väitti miehensä pahoinpidelleen hänen laillaan myös kahta aikaisempaa vaimoaan. Useat todistajat kertoivat oikeudelle, että Kellare ja hänen vaimonsa olivat olleet riitaisia siitä päivästä saakka, jolloin he olivat menneet naimisiin. He olivat tapelleet myös miehen kuolinpäivänä. Lisäksi vaimo oli halunnut kuristaa miehensä kaulaliinalla vain vähän aikaisemmin siitä hyvästä, että mies oli lyönyt häntä. Vaimo oli kutsunut miestään pyövelinruoaksi ja uhannut lyödä tätä päähän kuten Goljatia lyötiin.
Kellare oli valittanut puuseppä Johan Ööstille, että vaimo oli hakannut hänet aivan rikki. Vaimo oli lyönyt miestään jo aiemmin rautapuntarilla päähän. Vaimo oli sanonut todistaja Beata Mattsdotterille, että hänen miehensä tulisi kuolemaan kuluvana vuonna. Vaimo oli myös kehottanut Vääräjalan vaimoa Valborg Andersdotteria sanomaan, että hän oli ollut tämän luona miehen kuolinpäivänä maanantaina, vaikka hän oli ollut oman tyttärensä Anna kertoman mukaan kotona miehen kuollessa. Lisäksi hän oli valehdellut miehensä kuolinajan, sillä tämä oli ryypännyt kello kymmeneen Vääräjalan kanssa ja tapellut vielä puolilta päivin vaimonsa kanssa.
Lääketieteen professori Laurentius Bruchsin ja välskäri Johan Delfendahlin tutkimuksen mukaan ruumiin viisi verihaavaa kasvoissa ja jäljet kaulassa antoivat olettaa hänen kärsineen väkivaltaa ennen kuolemaansa. Vaimo tuomittiin Raastuvan kaaren 24 luvun perusteella vannomaan kolmantena raastupapäivänä itse kahdentenatoista, ettei hän ollut aiheuttanut miehensä kuolemaa. Lopullisessa tuomiossaan raastuvanoikeus totesi, ettei ollut syytä olettaa vaimo Marian surmanneen miehensä.

Raastuvassa käsiteltiin lokakuussa 1696 pyöveli Erik Lijtenin vaimon valitusta, jonka mukaan mies oli pahoinpidellyt häntä ja maannut edellisen pyövelin Matts Tasaisen piian Gertrud Jöransdotterin. Lijten kiisti makaamisen, kuten Gertrudkin, joka ilmoitti aivan toisen miehen makaajakseen. Lijten, joka oli karkotettu kaupungista, sanoi palanneensa kaupunkiin karkotuksesta huolimatta, sillä hänen hevosensa oli jäänyt Turkuun uuden pyövelin Jöran Keikelin hoitoon. Hän pyysi päästä pois vankilasta, sillä hän aikoi matkustaa heti Helsinkiin, jonne hänet oli valittu pyöveliksi. Oikeus totesi, että Lijtenin vaimo oli ollut humalassa ja kiivastuksissaan, kun hän oli ilmiantanut miehensä. Vaimo vetikin sanansa takaisin ja pyöveli päästettiin vankeudesta, ja hänen käskettiin heti poistua kaupungista.
Raastuvanoikeus määräsi hovioikeuden tuomion mukaan 13. helmikuuta 1711 pellavakankuri Elias Eliasson Krydman vannomaan, ettei hän ollut syyllinen vaimonsa Brita Mattsdotterin kuolemaan. Suomalainen kappalainen Simon Sadenius todisti, että Krydma oli kertonut elävänsä epäsovussa vaimonsa kanssa siksi, että tämä halusi antaa miehensä koko omaisuuden omille lapsilleen edellisestä avioliitosta. Krydma kielsi kuitenkin tappaneensa vaimoaan tämän takia.

Vanhempien ja lasten tulehtuneet välit
Coco Pyhä Raamattu (1642)
Vanha Testamentti
Toinen Moxeksen Kirja
XXI. Lucu.
2:21:15 JOca lyö Isäns taicka äitiäns/ hänen pitä totisest cuoleman.
Lasten tuli kunnioittaa vanhempiaan ja kohdella heitä lapsen kuuliaisuudella ja rakkaudella. Jos aikuinen lapsi nousi vanhempaansa vastaan, rikkoi hän Jumalan antamia käskyjä ja maallista lakia. 1600-luvun oloissa tämä tarkoitti kuolemanrangaistusta. Hovioikeus kuitenkin lievensi sen yleensä koviksi sakoiksi. Vanhempien ja lasten väliset suhteet nousevat usein esille oikeusistuinten pöytäkirjoissa. Suurimmaksi osaksi ne kertovat välittämisestä ja kiintymyksestä sekä vanhempien puolustamisesta, mutta toisinaan niistä ilmenee häiriötekijöitä, jotka voivat johtua niin vanhemmista kuin lapsistakin.
Esimerkiksi Nils Johansson Silli ja hänen vaimonsa Lisbeta Brusiusdotter valittivat lokakuussa 1660 miehen pojasta Jakob Sillistä ja tämän vaimosta Kirstin Simonsdotterista, että nämä olivat tapelleet vanhempien kanssa. Kun Nilsin vaimo Lisbeta oli ollut edellisen Birgitan päivän aikaan Uskelan markkinoilla, oli vaimo ollut Anjalan kylässä saunomassa Olof Suutarin talossa. Poikapuoli Jakob, joka oli majoittuneena naapuriin Knut Karvaisen taloon, oli tällöin heittänyt Lisbetan mukaan likavettä hänen päällensä ja haukkunut hänet pahanpäiväisesti. Vielä seuraavana päivänä, joka oli lauantai, oli poikapuoli ratsastanut Lisbetan mukaan Suutarille häiritsemään äitipuoltaan. Tämän saattoivat todistaa Suutari itse sekä hänen vaimonsa ja tyttärensä.
Jakob kielsi kaiken tämän ja sanoi äitipuolensa sepittäneen syytökset silkasta vihasta ja kateudesta. Jakob sanoi menneensä saunaan, mutta hän ei ollut tiennyt äitipuolensa olleen siellä. Lisbeta oli ollut lauteiden alla ja niiltä oli valunut vettä hänen päälleen. Vesi ei kuitenkaan ollut likaista, sillä sellaista ei lauteilla tietenkään ollut. Hän ei ollut myöskään puhutellut äitipuoltaan saunassa. Äitipuoli oli itse ollut humalassa ja yrittänyt haastaa riitaa hänen kanssaan kutsumalla Jakobia pukkivarkaaksi muiden haukkumasanojen ohella. Tämän saattoi todistaa messinkiseppä Jöns, joka oli ollut samaan aikaan kylpemässä lauteilla. Jakob kertoi olleensa seuraavana päivänä naapurissa keräämässä saataviaan talolliselta, eikä siinä tarkoituksessa, kuin äitipuoli väitti.
Vanha pari valitti edelleen, että Jakobin vaimo oli edellisenä päivänä, joka oli 18. lokakuuta, kello viiden aikaan iltapäivällä ollessaan pihalla kaivolla repinyt anoppipuoltaan hiuksista ja raapinut tämän kasvot aivan verille. Anoppi oli ollut tällöin kantamassa oluenpanokuurnaansa kotiin Thomas Hepo-ojan luota vaimo Karin Mattsdotterin kanssa. Lisbetan mukaan Kirstin oli lyönyt häntä kaivon koukulla olkapäille samalla, kun Jakob oli pidätellyt isäänsä, ettei tämä päässyt vaimonsa avuksi.
Kirstin vastasi, että hän oli ollut nostamassa vettä kaivosta antaakseen sitä hevoselle. Tällöin anoppipuoli oli tullut paikalle ja haukkunut häntä lapsenmurhaajaksi, kevytkenkäiseksi huoraksi ja pukkivarkaaksi. Naiset olivat päätyneet vähitellen toistensa hiuksiin kiinni. He olivat kynsineet toistensa kasvoja, kuten oikeus saattoi havaita niistä. Anoppi oli vielä sanonut, että mitä tekemistä Kirstinillä oli kaivolla, oliko hän mahdollisesti kaivanut sen. Vanha pari oli sitten seurannut häntä tuvan ovelle ja jättänyt kaivokoukun tuvan oven viereen, missä se oli vieläkin. Karin Mattsdotter sanoi nähneensä, kuinka Kirstin oli nostanut koukun ilmaan, mutta lyöntiä hän ei ollut nähnyt.
Jakob kertoi vielä, että äitipuoli oli ottanut kolme viikkoa aiemmin heidän avaimensa ovesta, kun he olivat rannassa aikoen lähteä hakemaan polttopuita Rymättylästä. Isä oli lisäksi heitellyt kiviä ikkunasta heidän tupaansa ja vienyt sieltä vuodevaatteet ja muuta tavaraa. Isä vastasi, että vuodevaatteet kuuluivat hänelle itselleen.
Messinkiseppä Jöns kertoi tulleensa yhtä matkaa kaupunkiin Jakobin kanssa ja menneensä tämän pihaan. Paikalle olivat heti ilmaantuneet ukko ja akka, jotka olivat aikoneet ottaa hänen tavaransa hevosen selästä väittäen niitä poikansa omiksi. He olivat karkottaneet hänet pihasta vihaisella koirallaan, joka heillä oli ollut mukana. He olivat vielä heitelleet hevosta kivillä ja haukkuneet poikaa kelmiksi ja aittavarkaaksi. Isä väitti oikeudessa, että poika oli vienyt häneltä leiviskän pellavia. Oikeus saattoi vain todeta, että ukko kutsui poikaansa istunnon aikana murhaajaksi ja paljoksi muuksi. Ukko vaati lisäksi rangaistusta pojalleen ja miniälleen ja niine hyvineen asia lähetettiin raastuvanoikeuteen ratkaistavaksi.
Asiassa otettiin miettimistauko ja toukokuussa 1661 Nils Johansson Silli perui syytteen ja sanoi, ettei poika ollut rikkonut millään tavalla vanhempiaan vastaan. Asia olisi ollut toteennäytettynä vakava, sillä isää ja äitiä vastaan nousemisesta annettiin kuolemantuomio. Hovioikeus tosin lievensi yleensä kuolemantuomiot korkeiksi sakoiksi. Muista Nils Sillin oikeudenkäynneistä päätellen hän oli itse väkivaltainen ja riidanhaluinen. Todistajien mukaan hän pahoinpiteli usein vaimoaan ja naapurit olivat valittaneet hänen rikkoneen myös heidän rauhaansa liialla kotikurilla huudon kiriessä pitkin katua. Kotikurin katsottiin ylittävän soveliaisuuden rajat, mikäli se häiritsi yhteisöä.

Mårten Storpinkan talossa tilanne oli vakavampi ja perheen piika Margareta Påvalsdotter valitti tammikuussa 1664, että Storpinkan poika Johan Mårtensson oli illalla 8. tammikuuta pahoinpidellyt häntä halolla. Tästä hänelle oli aiheutunut mustelma silmän alle, kuten oikeuskin saattoi todeta. Tämä oli johtunut siitä, että kun piika oli lähetetty hakemaan ruokatavaroita aitasta, oli Johankin mennyt sinne tarkoituksenaan ottaa sieltä jotakin, minkä hän voisi myydä hankkiakseen viinaa. Piika oli huomannut tämän heti ja kertonut asiasta pojan isälle. Johan oli käynyt piian päälle ja repinyt tämän mukaan myös äitiään Elin Thomasdotteria hiuksista niin, että paikalle oli ollut pyydettävä muuta apua.
Oikeus kuuli äiti, sillä isä Mårten oli sairaana vuoteessa. Äiti sanoi, ettei poika ollut noussut koskaan millään lailla vanhempiaan vastaan, mutta että hän piti humalassa meteliä ja vainosi talon vävyä Per Erikssonia ja sisartaan Lisbeta Mårtensdotteria sekä piikoja. Vävy kertoi Johanin haastaneen riitaa sisarensa ja piikojen kanssa ja lyöneen näitä avokämmenellä. Seuraavaksi hän oli aikonut vanhan isänsä kimppuun, mutta vävy oli estänyt sen lyömällä häntä kepillä selkään ja ajamalla ulos tuvasta. Vävyn mielestä Johan tuli pidättää, jotta väki saisi olla häneltä rauhassa.
Oikeus lähetti seuraavana päivänä edustajiaan kuulemaan isää, joka makasi vuoteessa lähellä kuolemaa. Isän mukaan poika vei talosta minkä pystyi, jauhot ikkunan kautta ja leivät vartaasta, myi ne kaupungilla ja ryyppäsi rahat. Johan oli vaatinut isältään rahaa ja Tapanina hän oli tullut keskiyöllä tupaan, jossa isä nukkui yksin. Hänellä oli ollut kädessään päre ja hän oli lähestynyt vuodetta sanoen vievänsä isänsä hengen nyt ja että tämän tuli tunnustaa syntynsä hänelle. Sen jälkeen Johan oli sammuttanut päreen hänen partaansa aikoen polttaa siten isäänsä. Isä oli kuitenkin saanut tulen sammutettua kädellään.
Poika oli murtanut kellarin oven vähän ennen Tuomaan päivää ja kantanut sieltä pytyillä ja punkilla olutta. Kun isä oli mennyt hätiin, oli hän tönäissyt tämän kiveen niin, että tämä valitti rintansa olevan edelleenkin kipeä. Äiti oli tullut nostamaan isän maasta ja auttanut tämän tupaan. Poika oli seurannut ja laulanut, kuin olisi ruumissaatossa. Isä oli todennut, että hän päätyisi vielä pyövelin ruoaksi. Johan oli todennut tähän, että mitäpä väliä sillä oli, sillä sinne hän halusikin.
Äiti pyysi, ettei isä olisi todistanut kaikkea tätä poikaansa vastaan, vaikka tämä olikin kohdellut isäänsä pahoin hulluudessaan. Isä sanoi säästäneensä poikaansa syytöksiltä tämän hulluuden vuoksi, mutta nyt hän ei enää aikonut tehdä niin, vaan antaisi asian Jumalan ja esivallan huomaan. Isä halusi pojan sanovan, minne hän oli piilottanut velkakirjan, jonka hän oli ottanut arkusta murrettuaan sen kirveellä. Johan kielsi kaiken tämän. Rahaa hän kertoi pyytäneensä isältään, mutta ei pahoinpidelleensä tätä. Oluttakin hän oli ottanut vain kannullisen, ja kellarin ovi oli auennut yhdellä potkaisulla, eikä hän ollut rikkonut sitä.
Isä Mårten Storpinkka lähetti helmikuussa edustajansa raastuvanoikeuteen anomaan armoa pojalleen. Isä pyysi, että poika päästettäisiin pois vankeudesta, sillä isä oli jo lähellä kuolemaa. Myös Johanin lanko Per Eriksson kertoi oikeudelle, että tämä oli isän toive. Isä asetti tosin ehdoksi sen, että poika karkotettaisiin kaupungista ikuisiksi ajoiksi, eikä hän saisi enää koskaan palata isän taloon. Oikeus harkitsi pyyntöä, mutta tuomitsi pojan sitten Jumalan lain mukaan kuolemaan hänen isää ja äitiä kohtaan osoittamastaan epäkunnioituksesta. Asia lähetettiin hovioikeuteen ja sen tuomio luettiin pojalle 9. maaliskuuta. Sen mukaisesti johan mestattiin 16. maaliskuuta 1664.

Johan Jöransson Rasiainen oli tammikuussa 1688 jo toistamiseen oikeudessa käyttäydyttyään anoppiaan Gertrud Persdotteria kohtaan asiattomasti. Anopilta kysyttiin, olko vävy lyönyt häntä tai haukkunut häntä. Anoppi vastasi, ettei häntä, vaan vaimoaan, hänen tytärtään. Mies oli lyönyt vaimoaan ja aikonut tehdä tälle pahaa vaimon palattua illalla kotiin, mutta anoppi oli estänyt enemmän pahoinpitelyn. Anoppi ilmoitti asian pormestarille, joka antoi haastaa Johanin oikeuteen. Anoppi vetosi korkeasti vävynsä syyttömyyden puolesta tällä kertaa. Johan vakuutti, että hän kohtelisi tästä päivästä anoppiaan pojan kuuliaisuudella. Vaimoaan hän lupasi kohdella kuten miehen tuli. Johan vapautettiin tällä kertaa, mutta hänelle luvattiin, että jos hän joutuisi uudelleen oikeuteen tästä samasta syystä, olisi tuomio sitä ankarampi.
Bertil Jakobsson Mängin vaimo Karin Grelsdotter valitti, että heidän vävynsä Jöran Bertilsson oli tullut 22. maaliskuuta 1689 puolen yön paikkeilla kotiin Kivisillasta aivan juovuksissa. Jöran oli ensin pahoinpidellyt vaimoaan Annaa, ja kun tämä oli hakenut turvaa yösijallaan olleelta vanhalta isältään Bertililtä, oli vävy repinyt appensa hiuksista vuoteesta. Hän raahasi apen pihalle ja pahoinpiteli päähän niin, että tämän toipumisesta oli vain vähän toivoa.
Vävylle vaadittiin rangaistusta, sillä hän oli tehnyt samalla tavoin ennenkin ja luvannut aina parantaa tapansa, mutta ei ollut tehnyt niin. Vävy ei voinut kieltää tekoaan, mutta kertoi, että sen jälkeen, kun hän oli maannut kaksi vuotta kovassa poltetaudissa, hän oli tullut aivan heikoksi niin, ettei hän kestänyt lainkaan paloviinaa. Appivanhempiaan hän ei syyttänyt tästä heidän välisestään riidasta, vaan sanoi lankonsa räätäli Matts Mängin aiheuttaneen sen.

Henrik Jakobsson Vääräjalka valitti isänsä pahoinpidelleen hänet 15. elokuuta 1690. Kun Henrik oli mennyt isänsä luo kello kymmenen aamupäivällä ostamaan oluttuopillista, oli isä maannut vuoteessa piika Valborg Andersdotterin kanssa. Poika ei ollut sanonut asiasta mitään, mutta kun kengitysseppä ja talollinen olivat menneet pois, oli Henrik varoittanut isäänsä piian kanssa makaamisesta. Tällöin isä oli ottanut halon ja lyönyt häntä selkään. Kun Jakob otti halon pois isältään, tarttui tämä poikaa hiuksiin ja heitteli ympäri pihaa. Poika piti kiinni isänsä paidasta, joka repesi.
Oikeudessa Jakob Vääräjalka kielsi maanneensa Valborgin kanssa, sillä piika ei hänen mukaansa ollut edes kotona tuona päivänä. Valborg tunnusti itse, että hän oli kyllä kotona, mutta makaamisen hän kielsi. Talon saunassa lastaan hoitamassa ollut Henrikin vaimo Brita Persdotter kertoi kuulleensa pihalta meteliä ja pistäneensä päänsä saunan ikkunasta ulos. Hän oli nähnyt miehensä makaavan pihalla ja appensa tämän päällä. Hänen miehensä oli juossut tupaansa ja isä halko kädessä tämän perään.
Kun Britan piti sitten mennä samana päivänä valittamaan hätäänsä pormestarin luo, oli appi kaatanut hänet nurin kadulla Festingin kulmassa. Appi potki tällöin miniänsä molempiin käsivarsiin mustelmat. Todistaja kaupunginpalvelija Erik Kalkkila sanoi kuulleensa ainoastaan sen, että appi oli uhannut lyödä Britaa, jos saisi tämän kiinni.
Pahoinpidellyt piiat
Piian asema isäntänsä ja emäntänsä taloudessa oli tarkoin määritelty. Luterilainen uskonto korosti kuuliaisuutta ja nöyryyttä, jota lapsen asemassa olevan palvelijan oli osoitettava isän ja äidin asemassa olevaa isäntäväkeään kohtaan. Heitä vastaan ei saanut nousta. Kotikuri kuului jokapäiväiseen elämään ja sen katsottiin parhaiten pitävän väen ruodussa ja opettavan heille kuuliaisuutta. Kotikuriin kuului ruumiillinen kurittaminen, mutta se ei saanut äityä pahoinpitelyksi. Piiat olivat enimmän aikaa tiukasti isäntäväkensä silmien valvonnassa, eivätkä he saaneet poistua talouden ulkopuolelle ilman lupaa. Tiivis yhdessäolo aiheutti hakausta osapuolten välille. Mikäli piiat tunsivat kokeneensa ylenmääräistä väärää kohtelua, toivat he asian säännönmukaisesti oikeuden ratkaistavaksi.
Esimerkiksi porvari Erik Henrikssonin vaimo oli pahoinpidellyt kovin entisen piikansa Brita Jöransdotterin syyskuussa 1642, joka oli palvellut häntä uskollisesti kaksi vuotta. Kun Brita oli lähtenyt laillisena pestuuaikana toisen palvelukseen ja mennyt hakemaan vaatteitaan entisestä palveluspaikastaan, oli emäntä hyökännyt hänen kimppuunsa lyönnein ja ryövännyt kaikki hänen vaatteensa. Emäntää näpäytettiin kuuden markan sakolla ja hänen tuli palauttaa vaatteet.
Jalosyntyisen ratsumestari Henrik Falckenhagenin piiat Ingeborg Hansdotter ja Lisbeta Urbansdotter olivat puolestaan rangaistusta pelätessään paenneet palveluksesta viikkoa ennen joulua 1666, sillä emäntä Ebba Maria Fleming oli jo pahoinpidellyt Lisbetan ja Ingeborg oli polttanut vahingossa talon saunan, mistä hän pelkäsi saavansa pahanpäiväisen selkäsaunan.

Lääkäri Tobias Kompstin vaimo Anna Maria pahoinpiteli maaliskuussa 1668 piikansa Margareta Månsdotterin niin, että tämä makasi vuoteessa eikä hänen toipumisensa ollut varmaa. Parturi Hans Roggenboch tutki piian ja totesi, ettei tässä ollut mustelmia, haavoja tai turvotusta, joten tämä paranisi.
Piiat Valborg Bertilsdotter ja Lisbeta Johansdotter valittivat kesäkuussa 1690, että heidän isäntänsä porvari Mårten Anung oli pahoinpidellyt heitä ja erityisesti Valborgia, joka esitti mustelmansa oikeudelle. Sen jälkeen isäntä oli ajanut heidät pois kotoa. Anung sai Valborgin lyömisestä 12 hopeamarkan sakon.
Piika Anna Larsdotter vaati syyskuussa 1693 kaupungin tuomiovallan alaisuuteen kuuluvalta Sotalaisten isännältä Erik Abrahamssonilta palkkaansa, jonka hän oli ansainnut Erikin edellisen vaimon aikana. Erikin uusi vaimo Kirstin Eriksdotter pahoinpiteli Annan tästä syystä. Palkkavaatimus hylättiin, mutta Kirstin sai 12 hopeamarkan sakon kahdesta lyönnistä.
Piika Demott Nilsdotter taas kertoi kesäkuussa 1694 palvelleensa neljä vuotta välskäri Petter Wassilla, joka oli pahoinpidellyt häntä epäkristillisesti. Isäntä ei ollut myöskään päästänyt häntä tarpeeksi usein kirkkoon ja Demottin oli ollut siksi pakko lähteä palveluspaikastaan. Piika ei halunnut sopia isäntänsä kanssa, sillä hän ei saanut mitään rauhaa tämän talossa.

Kapteeni von Wadenfeltin piika Brita Stelijn, jonka hän oli palkannut edellisenä syksyllä 1694 avainpiiakseen puustelliinsa Kokemäen Pirkkalaan, jätti palveluspaikkansa ja palasi Turkuun. Todistajien mukaan Brita oli pahoinpidelty mustelmille ja Britan mukaan kapteeni oli lisäksi uhannut antaa renkiensä piiskata hänet. Oikeus vapautti Britan palvelusvelvollisuudesta.
Elin Henriksdotter kertoi helmikuussa 1660 olleensa viiden viikon ajan imettäjänä tulliesimies Anders Gustafssonin vaimolla Eleonora Kristina Karlsdotterilla. Tämä oli kuitenkin ajanut Elinin pois lyönnein ilman palkkaa. Emäntä väitti Elinin käyttäneen kamalaa kieltä päivittäin.
Jöran Thomasson Porsas syytti kesäkuussa 1660 Matts Kupin vaimoa Karin Fransdotteria 16-vuotiaan tyttärensä Lisbeta Jöransdotterin kuolemasta. Vaimo oli lyönyt tyttöä kolme kertaa selkään, sillä hän oli rikkonut paloviinaruukun. Lyönnit olivat sattuneet tyttöön ja tämä oli kertonut asiasta isälleen ja äitipuolelleen. Lisbeta ei tullut tämän jälkeen terveeksi ja hän kuoli sunnuntaina 27.5.1660. Kupin vaimo kertoi lyöneensä tyttöä kolme kertaa selkään avokämmenellä, mutta hänen mukaansa tämä ei voinut kenenkään ihmisen mielestä aiheuttaa kuolemaa. Kupin vaimon mukaan Lisbeta oli valittanut kipeää kurkkuaan kaksi viikkoa ennen lyömistä, ja mennyt lainaamaan sudenkurkkua Nils Salakalta juodakseen sen läpi.
Lars Skomakaren 12-vuotias tytärpuoli Margareta Jakobsdotter kertoi, että edesmennyt oli valittanut pääkipua ja särkyä selässään, sillä emäntä oli lyönyt häntä nyrkillä. Emäntä oli myös kieltänyt edesmennyttä kertomaan kenellekään, että häntä oli lyöty. Matts Kupin vaimo totesi, että jos hän käyttäytyi kuten tyranni, niin tuskin kukaan tulisi toista kertaa palvelukseen samaan paikkaan, kuten Lisbeta oli tehnyt. Kun oikeus tarkasti ruumiin, se oli turvonnut ja mustelmilla.

Asessori Johan Wasseniuksen piika Annika Henriksdotter levitti huhtikuussa 1663 kaupungilla sanaa, että asessorin vaimo oli oikea tyranni. Kysyttäessä Annika sanoi jättäneensä palveluspaikkansa, sillä hänen emäntänsä löi häntä.
Piika Margareta Johansdotter oli pestautunut David Guldsmedin palvelukseen syksyllä 1662. Piika pakeni palveluksesta jo kolmen viikon kuluttua. Margareta ilmoitti jättäneensä paikkansa, sillä hänen emäntänsä oli usein uhannut lyödä Margaretaa hänen laiminlyöntiensä vuoksi.
Matts Larssonin vaimo Margareta Jakobsdotter oli aiheuttanut joulun pyhinä piialleen Maria Mårtensdotterille haavan sormeen puukolla. Emäntä oli halunnut leikata piian nahkajakun rikki puukollaan. Piian mukaan emäntä oli suuttunut hänelle, kun hän oli tehnyt reiän saunan kalvoikkunaan. Emäntä tuomittiin maksamaan haavan sakko 12 markkaa kaksinkertaisena, sillä hän oli rikkonut joulurauhaa.
Erik Johanssonin leski Annika Henriksdotter tunnusti heinäkuussa 1668 heittäneensä harjalla piikaansa Cecilia Larsdotteria niin, että tälle tuli haava otsaan. Tämä oli tapahtunut siksi, että piika oli istunut penkillä kehräämässä ja tullut nukahtaneeksi ja kuorsanneeksi. Tämä oli tapahtunut kello kymmenen aamupäivällä. Emäntä sai tästä 12 hopeamarkan sakon.

Porvari Jöran Hansson Hurulan piika Gertrud Markusdotter ilmoitti kesäkuussa 1686 lähteneensä palveluspaikastaan ennen aikojaan kahden Hurulassa vuokralla asuvan ylioppilaan Ericus Jordeliuksen ja Abrahamus Kosteniuksen kiusaamisen vuoksi. Lopulta ylioppilaat olivat estäneet hänen ruokarauhansakin. Kun hän aikoi viedä lusikan suuhunsa, olivat he seisseet hänen takanaan ja tönineet häntä. Kun isäntä ja emäntä eivät olleet puolustaneet Gertrudia, oli hän vienyt tavaransa sukulaisensa luo.
Gertrud ilmoitti kyllä haluavansa palvella vuotensa loppuun, mikäli hänet vielä huolittaisiin ja kohtelu muuttuisi. Hurulan toinen piika Agneta Eriksdotter kertoi kiusaamisen olevan totta. Jordeliuksen mukaan kiusaaminen johtui siitä, ettei Gertrud ollut laittanut rahaa köyhäinlippaaseen, kuten hänen olisi kuulunut. Lisäksi Gertrud käyttäytyi niin, että häntä oli ojennettava. Oikeus katsoi palvelusasetuksen viidennen kohdan perusteella, että Gertrud sai palata palvelukseensa, sillä isännällä ei ollut syytä erottaa häntä.
Piika Anna Mickelsdotter kertoi toukokuussa 1688, että kun hänen emäntänsä Lisbeta Sarath oli pessyt itseään sunnuntaina, hän oli jättänyt puolen dukaatin painoisen kultasormuksensa savupiipulle. Sormus oli sitten kadonnut kirkonmenojen aikaan. Emäntä oli hakannut piikaansa ja ottanut tämän arkun ja tavarat itselleen ja pakottanut hänet maksamaan sormuksen. Anna sanoi, ettei emäntä tiennyt, oliko hän jättänyt sormuksen kotiin vai hukannut sen kirkkomatkalla. Siksi hän halusi emäntänsä vannovan asiassa.
Vaimo Lisbeta Sarath kertoi sormuksen maksaneen kultasepällä yhdeksän taalaria, mutta hän oli sopinut piian kanssa kuudesta taalarista. Emäntä kielsi pantanneensa piikansa tavaroita, mutta kaksi lyöntiä hän oli tälle antanut, sillä tämä oli antanut avata ja lukea emännälle osoitetun kirjeen hänen ollessaan poissa. Lisäksi piika oli paennut palveluspaikastaan ennen aikojaan.

Raatimies Michael Chorelius kertoi lokakuussa 1688 piika Brita Eriksdotterin vieneen pois vakkansa isännän katon alta. Kun piialta kysyttiin, miksi hän oli vienyt vakkansa pois isäntänsä talosta, kertoi hän emäntänsä kironneen häntä, kun hän oli kaatanut mäskin. Hän oli lisäksi kuullut puhuttavan, etteivät aiemmat piiat olleet pysyneet kauan talossa. Britalta kysyttiin, halusiko hän palata palveluspaikkaansa. Hän oli ensin hiljaa, mutta vastasi sitten ei, sillä hän pelkäsi emäntänsä nyt olevan hänelle kovempi. Raatimieskin arveli, että hän hoitaisi työnsä huonosti, sillä hän oli vienyt vakkansa pois. Piika tuomittiin maksamaan takaisin pestiraha ja hänelle luvattu palkka.
Piika Karin Grelsdotter kertoi menneensä Mikon päivän aikaan 1690 puoleksi vuodeksi palvelukseen Mickel Wargin vaimolle Anna Jöransdotterille. Kun hän oli lähdössä palveluksesta, oli emäntä lyönyt häntä. Anna sanoi, että piika oli ottanut pestin koko vuodeksi. Anna myönsi lyöneensä piikaa kerran tämän laiminlyöntien ja suuren suun vuoksi. Oikeus määräsi Karinin palaamaan palvelukseen tai maksamaan emännälleen puolen vuoden palkan viisi taalaria.
Katselmuskirjuri Johan Nyholmin piika Valborg Jöransdotter sai horkkakohtauksia joka toinen päivä, ja hän oli siksi lähtenyt paikastaan keväällä 1695. Nyholm halusi hänet heti takaisin palvelukseen ja lupasi jättää hänet rauhaan horkkapäivinä. Piika sanoi, ettei hän voisi palata, sillä emäntä oli liian ankara häntä kohtaan. Hän halusi palata vasta parannuttuaan ja oikeuskin taipui tähän.
Piika Maria Larsdotter kertoi toukokuussa 1695, kuinka kauppias Simon Lydeman oli antanut vangita jokin aika sitten Marian sulhasen teini Gregorius Thomaen löydettyään tämän piian tuota. Lydeman oli heittänyt piian ulos, eikä halunnut tätä enää palvelukseensa. Maria oli käyttäytynyt emäntäänsä kohtaan hävyttömästi ja sanonut tälle tämän käskiessä Mariaa pesemään astioita: ”Yöllä Nussitan, ia eij astioita pestä!” Maria kielsi täysin sanoneensa mitään tällaista. Lopulta Lydeman lupasi ottaa Marian takaisin palvelemaan vuotensa loppuun.
Piika Brita Mattsdotter vaati toukokuussa 1695 puolentoista vuoden palkkaansa porvari Johan Bertilsson Rasiaiselta. Porvari puolestaan väitti Britan paenneen palveluksesta ja hukanneen vällyn ja kullatun soljen. Välly oli Britan mukaan tuvan vintissä, eikä hän tiennyt siitä. Soljen hän löysi pihalta, ja toinen piika Maria otti sen häneltä ja lupasi antaa emännälle. Kun Brita istui tuvassa penkillä itkemässä, emäntä kysyi, miksi hän itki. Brita vastasi, ettei hän voinut enää olla Rasiaisella. Brita aikoi lähteä ulos, mutta emäntä veti hänet takaisin ja löi häntä kaksi kertaa avokämmenellä olkapäälle. Asia järjestyi siten, että Brita pyysi tilalleen palvelukseen piika Sofia Mattsdotterin, joka otti pestin vastaan.
Piika nousee emäntäänsä vastaan
Piiat nousivat toisinaan emäntäänsä vastaan. He osasivat vaatia oikeudessa palkkasaataviaan ja he valittivat ruoan vähyyttä tai raskasta työtä. Toisinaan he menivät niin pitkälle teoissaan, että emäntä haastoi heidät oikeuteen. Tällöin he olivat ylittäneet tietyt sallitun rajat, sillä emäntä käsitettiin heidän äitinsä asemassa olevaksi sekä työnantajaksi, jota tuli ehdottomasti totella ja kunnioittaa lain ja säädösten sekä kirkollisten ohjeiden mukaan. Isän tai äidin lyömisestä saattoi saada siten kuolemantuomion joten kyse oli vakavasta rikoksesta. Turun hovioikeus kuitenkin lievensi rangaistuksen pääasiassa sakoiksi. Useimmiten riidat kuitenkin tuomittiin vain alioikeudessa.
Catechimus (1607)
I Kymmennen Jumalan käskyt
Nelies/
Cunnioita sinun Isäs ja Eitiäs / ettäs mänestyiset / ja olisit pitkä ijälinen maan pällä.
Kauppias Johan Angermanin vaimo Margareta Mattsdotter väitti heinäkuussa 1686 piikansa Lisbeta Eskilsdotterin tönäisseen hänet kumoon, mistä syystä emäntä oli antanut hänelle joitakin korvapuusteja. Piika oli jatkuvasti vastahakoinen toimittamaan emäntänsä antamia tehtäviä. Piika oli soittanut suutaan emännän valtuutetun mukaan ja saanut siitä muutamia korvapuusteja. Oikeus totesi hänen päässään useita verihaavoja, jotka emäntä oli iskenyt kauppapuodin avaimella. Oikeuden mukaan tarpeellista kotikuria sai noudattaa, mutta ei hakata palvelusväkeään siniseksi ja veriseksi. Siksi Margareta Mattsdotter tuomittiin Tahtohaavain Kaaren 9. luvun mukaan kaksi kertaa 12 hopeamarkan sakkoon kahdesta verihaavasta. Lisäksi todettiin, että mikäli vaimo Margareta ei enää haluaisi pitää piikaansa, tulisi tämän silti saada koko palkkansa.

Karduaaninahantekijä Joachim Boukten piika Karin Andersdotter käyttäytyi keväällä 1640 sopimattomasti palveluspaikassaan ja vääntänyt emäntänsä kädet sinisiksi, kun tämä halusi ojentaa häntä asiattomuuksista. Karin tuomittiin 12 markan sakkoon ja häntä varoitettiin enää käyttäytymästä sopimattomasti.
Simon Johanssonin vaimo Karin Grelsdotter valitti marraskuussa 1667 piikansa Elin Brusiusdotterin käyneen edellisenä iltana hänen kimppuunsa. Vaimo tuli illalla kello seitsemän kotiin häistä, joissa hänen miehensä oli kahvarina. Piika puri emäntää sormeen, raapi hänen kasvonsa ja korvansa sekä kaatoi hänet kumoon epäkristillisestä. Tämä johtui siitä, että emäntä pyysi piikaansa tekemään tulen ja lämmittämään kaalia. Piika sanoi, että onkos sinulla nyt nälkä, etkös saanut ruokaa häissä. Emäntä löi piikaa tällöin kaksi kertaa avokämmenellä.

Piika puolustautui ottamalla rukin ja lyömällä sillä muutaman kerran emäntää, joka pakeni naapuriin. Emäntä lähetti sieltä erään itsellisnaisen katsomaan lastaan, sillä hän ei uskaltanut itse mennä kotiin. Elin sanoi, ettei hänellä ollut mitään kädessään, millä lyödä emäntää, vaan hän oli ainoastaan purrut tätä. Vaimo Agneta Olofsdotter kertoi Elinin palvelleen kolme vuotta aiemmin kapteeni Bengt Perssonilla ja olleen tuolloin heikkopäinen.
Pistooliseppä Per Anderssonin vaimo Margareta Erlandsdotter ja hänen piikansa Sofia Mårtensdotter päätyivät puolestaan lokakuussa 1670 tappelemaan. Piika kutsui emäntää juopporatiksi ja emäntä piikaa kevytkenkäiseksi huoraksi. Naiset myös löivät toisiaan. Syynä tähän oli se, että emäntä moitti piikaa tämän rikkomuksesta. Piika sai 24 markan sakon kahdesta mustelmasta ja emäntä kuusi markkaa korvapuustista.
Piika Brita Thomasdotter valitti kesäkuussa 1681 emäntänsä Katarina Staren lyöneen hänelle kasvoihin haavan. Piika halusi päästä palveluspaikastaan ja vaati emäntäänsä rangaistavaksi. Emäntä sanoi joutuneensa huomauttamaan piialleen taitamattomuudesta ja laiskuudesta töissään. Kun piika sitten löi hänen lastaan, oli emännän pakko lyödä piikaansa. Verihaavaa hän ei mielestään ollut aiheuttanut. Brita sanoi lyöneensä emäntänsä poikaa leikillään, mutta hänet tuomittiin siitä silti kuuden markan sakkoon. Hänen tuli palvella vuotensa loppuun tai maksaa vuosipalkkansa yhdeksän taalaria emännälleen. Emänä sai puolestaan 12 markan sakon haavasta.
———
FT Veli Pekka Toropainen on Turun yliopiston arkeologian ja Suomen historian tutkija, joka on erikoistunut Turun 1600-luvun historiaan.
Lähteet:
Alkuperäislähteet
Kansallisarkisto (Helsinki)
Raastuvanoikeuksien renovoidut pöytäkirjat
Turun kämnerinoikeuden pöytäkirjat 1642-98 (KA z:172-z:205)
Turun kaupunginarkisto (Turku)
Turun maistraatin arkisto
Turun raastuvanoikeuden pöytäkirjat 1624─70 (BIa 1−BIa 39)
Kirjallisuus:
Carelius, Simon Johannis 1607: Catechimus. Se on Christilisen opin Pää cappaleet / D. Martinus Lutherin ulostoimituxen cansa / Soomen kielen tulkitut. Lyhykäisen Esipuheen cansa /iosa yxikertaisesta tiettäväxi tehdän/quinga itse cukin Christitty/hänens suren hödytyxen cansa ioca päivä Catechismuxessa harioitta machta. Simonis Iohannis Carelii culutuxel ulos käynyt/ia Prentätty Rostokissa Staffan Mylly mieheldä/Våånna Christuxen syndymän jälken. clc lcC VII. Sächsische Landesbibliothek – Staats- und Universitätsbibliothek Dresden.
Coco Pyhä Raamattu 1642: Nettiraamattu. Suomalaisia Raamatunkäännöksiä. Luettu 18.1.2020.